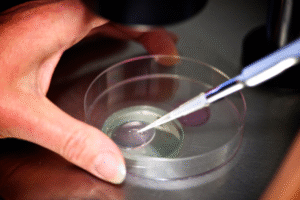

Shopping cart
Subscribe to out newsletter today to receive latest news administrate cost effective for tactical data.
2478 Street City Ohio 90255
Subscribe to out newsletter today to receive latest news administrate cost effective for tactical data.
2478 Street City Ohio 90255
GBR Fertility Cenrtre, offers cutting-edge IVF treatment with personalised care plans to help you achieve your dream of having a baby. Our state-of-the-art facility and experienced fertility specialists deliver exceptional success rates through evidence-based protocols.
In Vitro Fertilization (IVF) is a highly effective assisted reproductive technology where:
· Customized hormone injections
(8-12days)
· Regular monitoring via ultrasound & blood tests
· Mild sedation procedure (15-20 minutes) · Ultrasound-guided follicular aspiration
· Conventional IVF or ICSI (for male factor) · Embryo culture in time-lapse incubators
· Painless catheter procedure · Single embryo transfer recommended
· Blood test 12 days post-transfer · Early ultrasound confirmation

Certified cleanroom environment

Tailored to your unique needs

Zero reported infections

No hidden costs

Dedicated counselling services
💐 As we celebrate 20 years of miracles, GBR Fertility Centre thanks every patient, family, doctor, and well-wisher who has been part of our journey. GBR Fertility Centre & Hospitals has been a beacon of hope for countless families, transforming dreams of parenthood into reality. As we proudly celebrate our 20th Anniversary, we look back with gratitude and look ahead with renewed commitment to advancing reproductive healthcare.

A: 8-15 on average, depending on ovarian reserve
A: No, IVF babies have same risks as natural conception
A: Under 35, but we've helped women up to age 45+
A: Only for medical reasons per Indian regulations
A: 4-6 weeks from start to pregnancy test




 ACADEMIC REGISTRATION
ACADEMIC REGISTRATION

